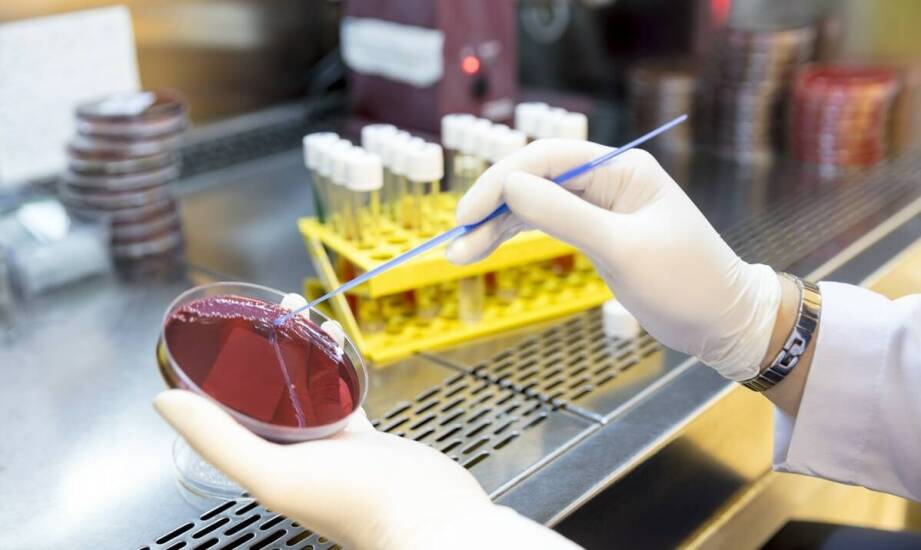
Badania na grzybicze infekcje: kompleksowa diagnostyczna oferta

Artykuł sponsorowany
Badania na grzybicze infekcje: kompleksowa diagnostyczna oferta
W ostatnich latach obserwuje się wzrost liczby przypadków zakażeń grzybiczych, co wpływa na zdrowie pacjentów. Infekcje te mogą być trudne do zdiagnozowania i leczenia, dlatego ważna jest kompleksowa oferta diagnostyki. Celem artykułu jest przedstawienie różnych badań wykrywających te infekcje oraz omówienie ich znaczenia w medycynie. Dzięki nowoczesnym metodom diagnozowania lekarze mogą skuteczniej identyfikować problemy zdrowotne, co potwierdza rosnące zainteresowanie nimi.
Metody diagnostyczne w wykrywaniu grzybów
W diagnostyce infekcji grzybiczych stosuje się różnorodne metody w celu ich wykrywania. Tradycyjne techniki laboratoryjne, takie jak hodowle grzybów czy testy serologiczne, są nadal powszechnie używane. Hodowle pozwalają na identyfikację patogenów poprzez ich rozmnażanie w kontrolowanych warunkach, natomiast testy serologiczne opierają się na wykrywaniu przeciwciał we krwi pacjenta. Nowoczesne metody molekularne, takie jak PCR (reakcja łańcuchowa polimerazy), zyskują jednak coraz większe uznanie. Pozwalają one na szybkie i precyzyjne wykrywanie materiału genetycznego grzybów, co jest szczególnie przydatne w przypadkach trudnych do zdiagnozowania. Skuteczność tych rozwiązań sprawia, że są one szeroko stosowane w praktyce klinicznej, umożliwiając lekarzom szybsze postawienie diagnozy i wdrożenie odpowiedniego leczenia.
Znaczenie szybkiej diagnostyki
Szybka i dokładna diagnostyka ma kluczowe znaczenie w leczeniu infekcji grzybiczych. Wczesne wykrycie problemu pozwala na skuteczniejsze terapie oraz zmniejsza ryzyko powikłań. Przykłady pokazują, jak odpowiednia diagnostyka uratowała zdrowie pacjentów. Należy podkreślić, że opóźnienia w identyfikacji mogą prowadzić do zaawansowanych stadiów choroby, co utrudnia leczenie i zwiększa ryzyko negatywnych konsekwencji dla zdrowia. Dlatego ważne jest korzystanie z usług specjalistów oferujących kompleksowe badania diagnostyczne w diagnostyce w Żorach, zwłaszcza w przypadku podejrzenia infekcji grzybiczej. W ten sposób można uniknąć poważnych problemów zdrowotnych oraz zapewnić sobie i bliskim odpowiednią opiekę medyczną. Szybka reakcja na objawy może uratować życie i zdrowie.
Kompleksowa oferta badań diagnostycznych
W Żorach pacjenci mają dostęp do szerokiej gamy badań diagnostycznych, które umożliwiają identyfikację różnych schorzeń. W kontekście infekcji grzybiczych oferowane są testy wykrywające obecność patogenów oraz oceniające ich oporność na leki. Laboratoria przeprowadzają także analizy dotyczące zakażeń bakteryjnych i chorób autoimmunologicznych. Korzystanie z usług specjalistów przynosi korzyści w postaci szybkiej diagnozy i odpowiedniego leczenia. Dzięki temu można uniknąć powikłań oraz poprawić jakość życia pacjentów. Diagnostyka Żory to kompleksowe podejście do zdrowia mieszkańców regionu.
Kategorie artykułów
Polecane artykuły

Skuteczne strategie zapobiegania zakamienieniu wymienników ciepła w instalacjach CO.
W instalacjach CO stosowane są nowoczesne metody odkamieniania, które umożliwiają skuteczne usuwanie osadów z wymienników ciepła. Jednym z rozwiązań są chemiczne środki czyszczące, które rozpuszczają kamień kotłowy i nie powodują uszkodzeń urządzeń. Ich zaletą jest wysoka wydajność oraz niska korozy

Jak różne typy trawników wpływają na wybór żyłki do kosiarki?
Wybór odpowiedniego typu trawnika jest kluczowy dla efektywności koszenia. Istnieje wiele rodzajów trawników, które różnią się wyglądem oraz wymaganiami pielęgnacyjnymi. Niektóre z nich są bardziej odporne na uszkodzenia, inne zaś wymagają częstszego koszenia. Zrozumienie tych różnic pomoże w doborz